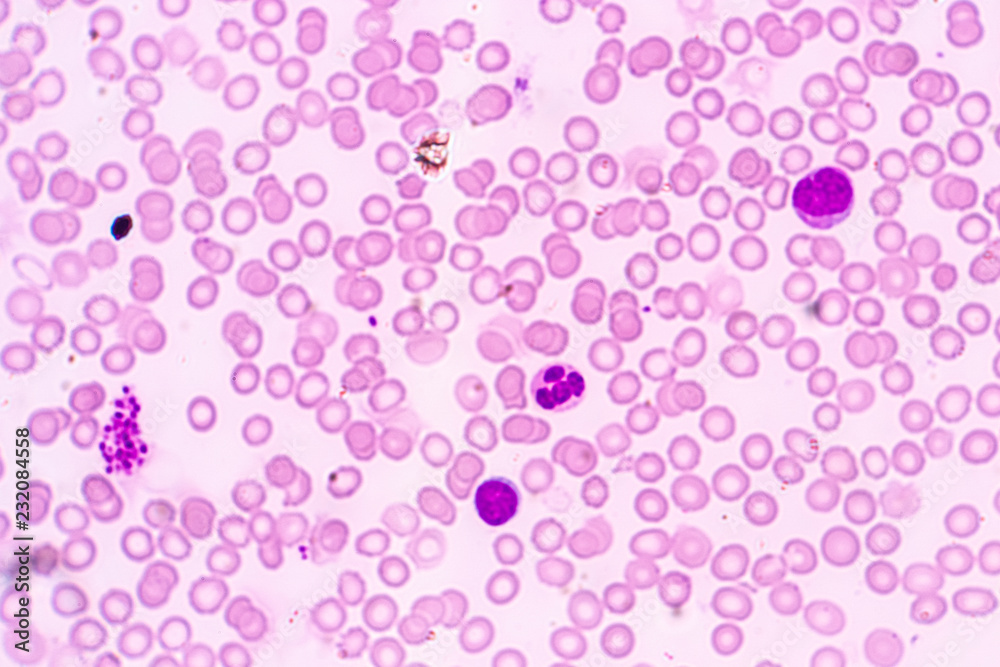

Изображения клеток с гемоглобином в микроскоп
































:format(webp)/cdn.vox-cdn.com/uploads/chorus_asset/file/14641919/white_blood_cell.0.1410206666.jpg)

Друзья, добро пожаловать в нашу галерею! Визуальные образы говорят громче слов, и наша коллекция картинок создана, чтобы вдохновлять вас и рассказывать уникальные истории. Каждая фотография и иллюстрация — это маленькое окно в мир идей, эмоций и красоты. На нашем сайте вы найдете моменты, запечатленные в кадре, которые останутся с вами навсегда, художественные интерпретации, которые пробуждают воображение и создают новое восприятие знакомых вам явлений. Наслаждайтесь просмотром, черпайте вдохновение и делитесь любимыми находками!